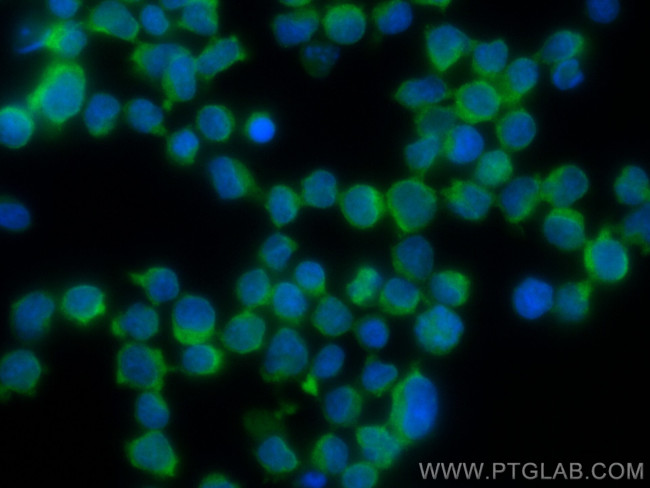
ARHGAP4 Antibody in Immunocytochemistry (ICC/IF)

Search
Proteintech
ARHGAP4 Polyclonal Antibody, CoraLite® Plus 488
{{$productOrderCtrl.translations['antibody.pdp.commerceCard.promotion.promotions']}}
{{$productOrderCtrl.translations['antibody.pdp.commerceCard.promotion.viewpromo']}}
{{$productOrderCtrl.translations['antibody.pdp.commerceCard.promotion.promocode']}}: {{promo.promoCode}} {{promo.promoTitle}} {{promo.promoDescription}}. {{$productOrderCtrl.translations['antibody.pdp.commerceCard.promotion.learnmore']}}
产品信息
CL488-16697
种属反应
宿主/亚型
分类
类型
抗原
偶联物
激发/发射光谱
形式
浓度
纯化类型
保存液
内含物
保存条件
运输条件
产品详细信息
Sequence of this protein is as follows: VALQGRVNQL VQTLIVQPDR VFPPLTSLPG PVYEKCMAPP SASCLGDAQL ESLGADNEPE LEAEMPAQED DLEGVVEAVA CFAYTGRTAQ ELSFRRGDVL RLHERASSDW WRGEHNGMRG LIPHKYITLP AGTEKQVVGA GLQTAGESGS SPEGLLASEL VHRPEPCTSP EAMGPSGHRR RCLVPASPEQ HVEVDKAVAQ NMDSVFKELL GKTSVRQGLG PASTTSPSPG PRSPKAPPSS RLGRNKGFSR GPGAPASPSA SHPQGLDTTP KPH
靶标信息
This gene encodes a member of the rhoGAP family of proteins which play a role in the regulation of small GTP-binding proteins belonging to the RAS superfamily. The protein encoded by the orthologous gene in rat is localized to the Golgi complex and can redistribute to microtubules. The rat protein stimulates the activity of some Rho GTPases in vitro. Genomic deletions of this gene and a neighboring gene have been found in patients with nephrogenic diabetes insipidus. Multiple transcript variants encoding different isoforms have been found for this gene.
仅用于科研。不用于诊断过程。未经明确授权不得转售。
篇参考文献 (0)
生物信息学
蛋白别名: GTPase-activating protein p115; p115; RG RhoGAP4; Rho GTPase-activating protein 4; Rho-GAP hematopoietic protein C1; Rho-type GTPase-activating protein 4
基因别名: A130009C12Rik; A530015A20Rik; ARHGAP4; C1; KIAA0131; mKIAA0131; p115; RGC1; RHOGAP4; SrGAP4
UniProt ID: (Human) P98171
Entrez Gene ID: (Human) 393, (Mouse) 171207